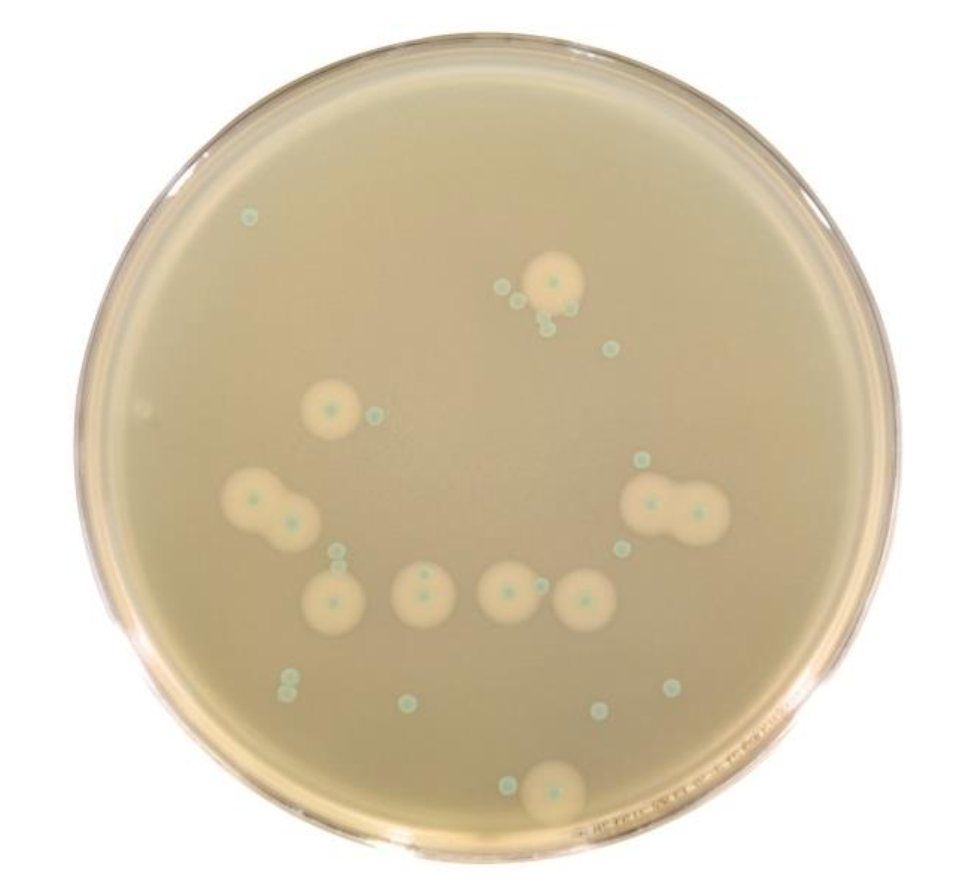

CRM019B Chromogenic Listeria Agar(OA)
$213.60-328.60
Chromogenic Listeria Agar(OA) Product No. Product Category CRM019B Dehydrated Culture Medium Intended Use For the enumeration, isolation, and confirmation of Listeria monocytogenes. Sp……
Introduction
Chromogenic Listeria Agar(OA) Product No. Product Category
CRM019B Dehydrated Culture Medium
Intended Use
For the enumeration, isolation, and confirmation of Listeria monocytogenes.
Specification
500g/bottle
Principle and Interpretation
| Peptone, soybean peptone, and yeast extract provide nitrogen sources and trace elements. Glucose serves as the carbon source. Sodium pyruvate, magnesium glycerophosphate, magnesium sulfate, and lithium chloride promote bacterial growth and regulate enzyme activity. Sodium chloride maintains osmotic balance. Disodium hydrogen phosphate acts as a buffer. Agar is the solidifying agent. The chromogenic substrate 5-bromo-4-chloro-3-indolyl-β-D-glucopyranoside reacts specifically with β-glucosidase produced by Listeria spp., releasing a chromogenic group to form green colonies. The supplementary reagents (SR0750) contain lecithin and antibiotics to inhibit non-target bacteria. Listeria monocytogenes, |
| which produces lecithinase, forms green colonies surrounded by a milky-white halo of precipitated lipids. |
Formulation
| Ingredients | /liter |
| Peptone | 18.0g |
| Tryptone | 6.0g |
| Yeast extract | 10.0g |
| Sodium pyruvate | 2.0g |
| Glucose | 2.0g |
| Magnesium glycerophosphate | 1.0g |
| Nalidixic acid | 0.02g |
| Polymyxin B | 76700IU |
| L-α-Phosphatidylinositol | 2.0g |
| Magnesium sulfate (anhydrous) | 0.5g |
| Sodium chloride | 5.0g |
| Lithium chloride | 10.0g |
| Disodium hydrogen phosphate (anhydrous) | 2.5g |
| 5-Bromo-4-chloro-3-indolyl-β-D-glucopyranoside | 0.05g |
| Agar | 15.0g |
Page 1 / 3
| Ceftazidime | 0.02g |
| Cycloheximide | 0.1g |
| pH 7.2±0.2 at 25°C | |
Preparation
Weigh 72.1g of dry powder and add to 950mL purified water. Stir and heat until fully dissolved (adjust proportionally for larger or smaller batches).Autoclave at 121°C for 15 minutes. Cool to approximately 50°C.Add 10 mL sterile purified water to each tube of supplementary reagent (SR0750). Vortex for 3-5 minutes to dissolve. Mix the dissolved reagent into 190mL of the cooled base medium. Pour into sterile Petri dishes and allow to solidify.
Quality Control
Cultural characteristics observed after incubation at 35-37°C for 24±3 hours
Storage and Shelf Life
2-8°C,Keep container tightly closed, avoid direct sunlight. Use before expiry date on the label.
Precautions
1. When weighing the dehydrated medium, please wear masks to avoid causing respiratory system discomfort 2. Keep container tightly closed after using to prevent clumping.
Waste Disposal
Microbiological contamination was disposed by autoclaving at 121°C for 30 minutes.
Revision
On June 14, 2024
Listeria monocytogenes: Smooth blue-green colonies with milky-white halos Other Listeria species: Blue-green colonies without a halo



